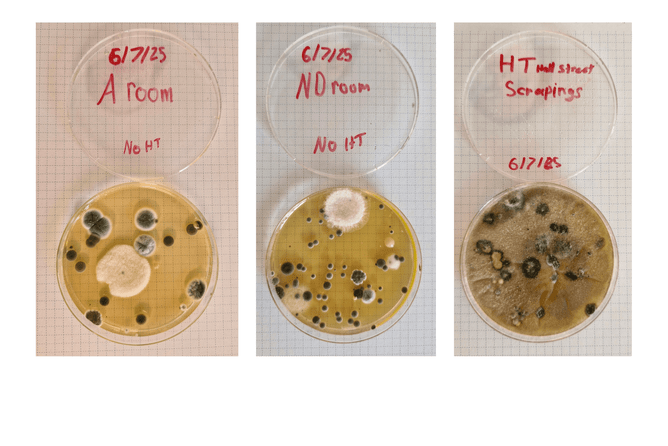
Petri Dish DIY test - The bedroom petri dishes were open for 1 hour, sitting on the floor of the room, then left sealed for 5 days. The HT scrapings were from the heat transfer intake in the lounge. The heat transfer had been turned off a month earlier and remained off.

The original purpose of Sustain Studio was to document the journey of our new home build and the sustainable choices we’re making along the way. But, as with any journey, sometimes the road takes an unexpected turn.
Ours came when we encountered mould—not in the new build, but in the rental we had planned to live in until our house was complete.
At $800 a week, the rental seemed decent enough from first glance—a typical 1980s home with single glazing and modest insulation. We moved in on May 1st and chose to use the heat pump instead of the fireplace at that time. Since both David and I work from home most of the time, we set up our desks in the lounge.
What we didn’t know was that the heat pump was contaminated with black mould. Every time we turned it on, we were unknowingly heating and circulating mould spores throughout the house—directly into our breathing space. Even worse, the heat transfer system was pulling this air past David’s desk and sending it straight into the bedrooms.
We had expected that living in an older, single-glazed home over winter would be a step down from the modern home we came from—but we never imagined it would affect our health so severely.
Soon, we were experiencing persistent symptoms. Headaches, sore throats, fatigue, and difficulty concentrating became daily struggles. I found myself anxious and emotional. David’s symptoms were even worse—constant coughing and debilitating headaches. The girls were also coughing and unsettled.
Concerned, we consulted both a doctor and a naturopath. They recommended toxin binders and probiotics for the whole family. That’s when things got even harder. David’s body went into full detox mode—shaking, sweating, suffering splitting headaches, and still coughing horribly.
Our lowest moment came when David was bedridden, completely wiped out by the detox. I was in tears at my parents’ house, feeling like we had nowhere safe to go.
So, we moved into solution mode.
We made the decision to purchase a small two-bedroom unit close to town, and began a three-week renovation to create a healthier space of our own. I’ll be sharing that renovation journey soon, before returning to the original build project. But for now, what happened next further confirmed that we’d made the right call.
After the heat pump had been professionally cleaned, we came across a simple DIY mould test. It involved placing a petri dish on the floor of a room for one hour, sealing it, and waiting five days to see what would grow.
Since we had been away for three nights, we thought there might not be many spores left floating around. And with the heat pump cleaned, from the landlord’s point of view, the problem was “fixed.”
But the test results told a very different story.
According to the guidelines:
Up to 5 spores is considered normal
5 to 9 spores signals a health concern
More than 9 is a serious health problem
Anika’s room had 23 spores.
Our bedroom had 59.
The sample taken from the heat transfer system overwhelmed the petri dish—it was uncountable.
It’s now clear the mould issue in that home is deeply embedded—far beyond just the heat pump. Solving it would require replacing soft furnishings, the entire heat transfer system, and potentially even wall linings and insulation.
This experience has only strengthened our commitment to creating a healthier home from the ground up. Taking control of our environment, even if it means diving into a renovation sooner than planned, is the right move for our family’s wellbeing.
This is not the journey we expected—but it’s one we’re now deeply invested in sharing. Because sustainability isn’t just about the energy rating of a new home. It’s about the everyday health and safety of the people living inside it.